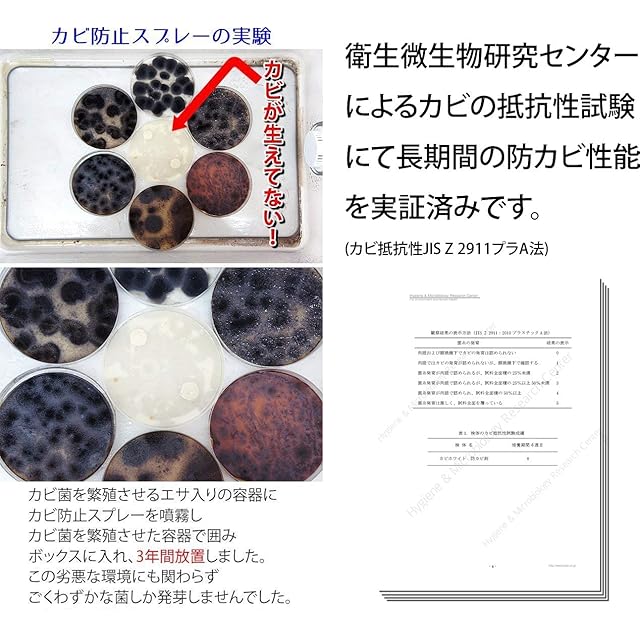

カビホワイト カビ防止スプレー[お風呂・室内・クローゼット・カーテン・下駄箱・押し入れ](300ml)
¥2,750 税込
SOLD OUT
この商品は送料無料です。
【商品概要】
【本製品について】様々な場所に使用できるカビの発生防止剤です。対象物にミクロのレベルで固着し長期間の間、アルコール成分が蒸発せずに留まり続けてくれ、カビやバクテリアを除菌し続けます。
【防カビ期間について】バスルームでも約1年間、室内なら約2~3年の防カビ効果が期待できます(湿気や環境によって防止期間は変わります)。※お風呂でも市販のお風呂洗剤とブラシを使った一般的なそうじレベルなら薬剤が剥がれることはありません。
【お掃除箇所の例】食器や食品以外ならほとんどの箇所に使用できます。※電子機器や桐ダンスなどの水分に弱いものや、ニスや塗料などでアルコールが使えない材質にも使用できません。それ以外の箇所でもご使用前に必ず30分以上のパッチテストをしてご確認ください。
【エアコンの防カビや靴の消臭剤としても】エアコン内部のカビやカビ臭を抑制できます。錆を抑える成分を配合しているので金属にも使用可能です。また、運動靴や革靴にもご利用いただけます。臭いの元になるバクテリアも除菌し続けますので、運動靴や革靴を清潔なまま使用できます。※モーターや電子機器に水分がかかると故障の原因になりますのでご注意ください。
【開発メーカーについて】おそうじ関連業務30年以上、ネット通販15年以上の企業、ビーワンコーポレーションが開発した本格派のカビ取り剤になります。
【商品説明】
住まいの防カビ。黒カビ・青カビ・赤カビ・緑カビ・白カビ、どんなカビにも対応。アルコールタイプで対象物に長期間留めることで、カビの菌糸だけでなくカビのエサとなるバクテリアすら発生することができなくなります。バスルームでも約1年間、室内なら約2~3年の防カビ効果が期待できます(湿気や環境によって防止期間は変わります)。
【商品詳細】
ブランド:ビーワンショップ
商品種別:ドラッグストア
商品名:カビホワイト カビ防止スプレー[お風呂・室内・クローゼット・カーテン・下駄箱・押し入れ](300ml)
製造元:ビーワンコーポレーション
商品番号:kabi-boushi300
商品内容:300ミリリットル (x 1)
梱包サイズ:36.2cm
-
送料・配送方法について
-
お支払い方法について
¥2,750 税込
SOLD OUT